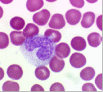

11832 (567614), страница 5
Текст из файла (страница 5)
Эти клетки экспрессируют FOXP3 - транскрипционный фактор, регулирующий транскрипцию генов, ответственных за дифференцировку Т-клеток и экспрессию цитокинов и других факторов, участвующих в супрессии иммунного ответа. Часто эти клетки так и обозначают, как FOXP3+ регуляторные Т-клетки (FOXP3+ Treg cells). Кроме того, важным маркером Т-регуляторных клеток является экспрессия на их поверхности рецептора к цитокину IL-2 - CD25, соответственно это обозначают как CD25+ клетки. Помимо этих основных маркёров Treg клетки на своей мембране экспрессируют CD62L, различные изоформы мембрано-связанной фосфатазы CD45. Различают несколько разных типов регуляторных Т-клеток: естественные Т-регуляторные клетки (T-reg1) и индуцибельные Т-регуляторные клетки (iT-reg). Индуцибельные Т-регуляторные клетки образуются под влиянием различных факторов на периферии, например, в региональных лимфатических узлах.
Для супрессии иммуного ответа Тreg клетки выделяют цитокины: TGF-beta, IL-10, IFNgamma, IL-35, а также экспрессируют на своей поверхности рецептор CTLA-4. Существуют несколько механизмов супрессии: прямой, при непосредственном контакте между клетками, и дистантный, осуществляющийся на расстоянии - например, через растворимые цитокины. Мишенями действия Тreg клеток являются как Т-эффекторные клетки, так и дендритные клетки, ответственные за презентацию антигена и активацию Т-клеток. При дистантном механизме цитокины, выделяемые Тreg клетками, например, трансформирующий ростовой фактор бета (TGF-beta), связываются со своими рецепторами на поверхности Т-эффекторных клеток и ингибирует их активацию, тем самым супрессируя иммунный ответ. Важным механизмом также служит захват IL-2 при помощи CD25 - рецептора к IL-2 и секвестрация рецептора у эффекторных Т-клеток, что препятствует активации после связывания комплекса MHC с антигеном, так как известно, что IL-2 является основным аутокринным стимулирующим фактором, поддерживающим диффернцировку и клональную экспансию Т-клеток.
Тreg клетки, взаимодействуя с рецептором CD86 на дендритных клетках при помощи CTLA-4, способны ингибировать функцию активации дендритными клетками Т-клеток.
При прямом механизме супрессии Treg взаимодействуют с эффекторными Т-клетками и гранзим B действует через перфорины, образующие канал, вызывая апоптоз в этих клетках, тем самым элиминируя активные Т-клетки.
Цитотоксические Т-лимфоциты непосредственно контактируют с чужеродными клетками и разрушают их. Клеточный иммунитет опосредован цитотоксическими Т-лимфоцитами и Т-хелперами. Многие микроорганизмы живут внутри клеток в недосягаемости для гуморальных антител. Чтобы справиться с внутриклеточными паразитами, возникла обособленная система приобретенного имунитета, основанная на функционировании отдельной субпопуляции лимфоцитов, а именно, цитотоксических T-лимфоцитов (T-киллеров). Эти клетки отличаются очень широкой специфичностью. Поскольку T-лимфоциты должны взаимодействовать с содержащими паразитов клетками, они могут узнать антиген только в том случае, если он экспрессирован на поверхности инфицированной клетки. Как и B-лимфоциты, каждая T-клетка имеет специфический рецептор, который распознает этот антиген. (Рецептор T-лимфоцита структурно отличается от молекулы мембраного иммуноглобулина - рецептора B-лимфоцитов). При этом T-лимфоциты узнают антиген на поверхности клетки в комплексе с клеточным маркером: молекулами MHC класса I. В процессе распознавания поверхностного антигена цитотоксический T-лимфоцит вступает в теснейший контакт со своей мишенью и уничтожает ее до начала репликации. Кроме того, он продуцирует гамма-интерферон, который ограничивает проникновение вируса в соседние клетки, особенно в тех случаях, когда вирус является слабым индуктором альфа-интерферона и бета-интерферона Цитотоксические T-лимфоциты относятся к субпопуляции T8 (или Ly2) и представляют популяцию T-эффекторов и играют важнейшую роль в уничтожении клеток, зараженных вирусами, бактериями, а возможно, участвуют и в предполагаемом надзоре за появлением опухолевых клеток.
Большинство цитотоксических T-клеток (Tц) относится к субпопуляции CD8+ и распознает антиген, презентированный в ассоциации с молекулами MHC класса I, но меньшая их часть (примерно 10%), относящаяся к субпопуляции CD4+, способна распознавать антиген в ассоциации с молекулами MHC класса II.
Для активации и поражения мишени Tц обладают несколькими механизмами воздействия. Один из них - это передача сигналов при непосредственном клеточном контакте через поверхностные структуры, другой - непрямая сигнализация с помощью цитокинов. Кроме того в цитоплазме многих цитотоксических клеток обнаружены гранулы с белками, высвобождение которых вблизи цитоплазматической мембраны клетки-мишени вызывает ее повреждение.
Цитотоксические T-лимфоциты развиваются из предшественников. Предшественники цитотоксических клеток активируются комплексом антигена и молекул MHC класса I, размножаются и созревают под действием IL-2, а также еще плохо идентифицированных факторов дифференцировки, продуцируемых T-хелперами.
Нулевые лимфоциты не имеют поверхностных маркеров на плазмолемме, характерных для В - и Т-лимфоцитов. Их расценивают как резервную популяцию недифференцированных лимфоцитов.
В настоящее время оценка иммунного статуса организма в клинике проводится с помощью иммунологических и иммуноморфологических методов выявления различных видов лимфоцитов.
Продолжительность жизни лимфоцитов варьирует от нескольких недель до нескольких лет. Т-лимфоциты являются "долгоживущими" (месяцы и годы) клетками, а В-лимфоциты относятся к "короткоживущим" (недели и месяцы). Для Т-лимфоцитов характерно явление рециркуляции, т.е. выход из крови в ткани и возвращение по лимфатическим путям снова в кровь. Таким образом они осуществляют иммунологический надзор за состоянием всех органов, быстро реагируя на внедрение чужеродных агентов. Среди клеток, имеющих морфологию малых лимфоцитов, следует назвать циркулирующие стволовые клетки крови (СКК), которые поступают в кровь из костного мозга. Впервые эти клетки были описаны А.А. Максимовым и обозначены им как "подвижный мезенхимный резерв". Из СКК, поступающих в кроветворные органы, дифференцируются различные клетки крови, а из СКК, поступающих в соединительную ткань, - тучные клетки, фибробласты и др.
Моноциты. Система мононуклеарных фагоцитов (СМФ).
В капле свежей крови эти клетки лишь немного крупнее других лейкоцитов (9-12 мкм), в мазке крови они сильно распластываются по стеклу и размер их достигает 18-20 мкм. В крови человека количество моноцитов колеблется в пределах 6-8 % от общего числа лейкоцитов.
Ядра моноцитов разнообразной и изменчивой конфигурации: встречаются бобовидные, подковообразные, редко - дольчатые ядра с многочисленными выступами и углублениями. Гетерохроматин рассеян мелкими зернами по всему ядру, но обычно в больших количествах он располагается под ядерной мембраной. В ядре моноцита содержится одно или несколько маленьких ядрышек (рис.8).
Рис.8. Моноцит.
Цитоплазма моноцитов менее базофильна, чем цитоплазма лимфоцитов. При окраске по методу Романовского - Гимзы она имеет бледно-голубой цвет, но по периферии окрашивается несколько темнее, чем около ядра; в ней содержится различное количество очень мелких азурофильных зерен (лизосом). Характерны наличие пальцеобразных выростов цитоплазмы и образование фагоцитарных вакуолей. В цитоплазме расположено множество пиноцитозных везикул. Имеются короткие канальцы гранулярной эндоплазматической сети, а также небольшие по размеру митохондрии. Моноциты относятся к макрофагической системе организма, или к так называемой мононуклеарной фагоцитарной системе (МФС). Клетки этой системы характеризуются происхождением из промоноцитов костного мозга, способностью прикрепляться к поверхности стекла, активностью пиноцитоза и иммунного фагоцитоза, наличием на мембране рецепторов для иммуноглобулинов и комплемента. Моноциты циркулирующей крови представляют собой подвижный пул относительно незрелых клеток, находящихся на пути из костного мозга в ткани. Время пребывания моноцитов в крови варьирует от 36 до 104 ч. Моноциты, выселяющиеся в ткани, превращаются в макрофаги, при этом у них появляются большое количество лизосом, фагосом, фаголизосом.
Из крови в ткани за 1 ч уходит 7,0-106 моноцитов. В тканях моноциты дифференцируются в органо - и тканеспецифичные макрофаги. Внесосудистый пул моноцитов в 25 раз превышает циркулирующий.
Система мононуклеарных фагоцитов является центральной, объединяющей различные типы клеток, участвующих в защитных реакциях организма. Макрофагам принадлежит важнейшая роль в процессах фагоцитоза. Они удаляют из организма отмирающие клетки, остатки разрушенных клеток, денатурированный белок, бактерии и комплексы антиген-антитело. Макрофаги участвуют в регуляции кроветворения, иммунном ответе, гемостазе, метаболизме липидов и железа. Содержание моноцитов в крови в норме отражено в табл.2.
Таблица 3.
Содержание лимфоцитов (абсолютное и относительное - процентное количество) в крови в норме
| Возраст | Предел колебаний, 10 /л | Моноциты, % |
| 12мес | 0,05-1,1 | 2-7 |
| 4 года | 0-0,8 | 2-7 |
| 10 лет | 0-0,8 | 1-6 |
| 21 год | 0-0,8 | 1-8 |
| Взрослые | а-0,8 | 1-8 |
Моноцитоз - увеличение числа моноцитов в крови (>0,8109/л) - сопровождает целый ряд заболеваний (табл.1.28). При туберкулезе появление моноцитоза считается доказательством активного распространения туберкулезного процесса. При этом важным показателем является отношение абсолютного числа моноцитов к лимфоцитам, которое в норме составляет 0,3-1,0. Это отношение бывает более 1,0 в активную фазу заболевания и снижается при выздоровлении, что позволяет оценить течение туберкулеза.
При септических эндокардитах, вялотекущем сепсисе возможен значительный моноцитоз, который нередко встречается в отсутствие лейкоцитоза. Относительный или абсолютный моноцитоз отмечается у 50 % больных с системными васкулитами.
Кратковременный моноцитоз может развиться у больных с острыми инфекциями в период реконвалесценции. Моноцитопения - уменьшение числа моноцитов (< 0,09109/л). При гипоплазии кроветворения количество моноцитов в крови снижено.
2.3 Постклеточные структуры
2.3.1 Эритроциты
Эритроциты, или красные кровяные тельца, человека и млекопитающих представляют собой безъядерные клетки, утратившие в процессе фило - и онтогенеза ядро и большинство органелл. Эритроциты являются высокодифференцированными постклеточными структурами, неспособными к делению.
Функции эритроцитов осуществляются в сосудистом русле, которое они в норме никогда не покидают:
1) дыхательная - транспортировка кислорода и углекислоты. Эта функция обеспечивается благодаря тому, что эритроциты заполнены железосодержащим кислород - связывающим пигментом - гемоглобином (составляет 33% их массы), который определяет их цвет (желтоватый у отдельных элементов и красный у их массы)
2) Регуляторные и защитные функции обеспечиваются благодаря способности эритроцитов переносить на своей поверхности ряд биологически активных веществ, в том числе иммуноглобулины, компоненты комплемента, иммунные комплексы.
3). Кроме того, эритроциты участвуют в транспорте аминокислот, антител, токсинов и ряда лекарственных веществ, адсорбируя их на поверхности плазмолеммы.
Форма и строение. Популяция эритроцитов неоднородна по форме и размерам (рис.9). В нормальной крови человека основную массу (80-90 %) составляют эритроциты двояковогнутой формы - дискоциты. Кроме того, имеются планоциты (с плоской поверхностью) и стареющие формы эритроцитов - шиловидные эритроциты, или эхиноциты (~ 6 %), куполообразные, или стоматоциты (~ 1-3 %), и шаровидные, или сфероциты (~ 1 %)
Рис.9. Формы эритроцитов.
Средняя продолжительность жизни эритроцитов составляет около 120 дней. В организме ежедневно разрушается около 200 млн эритроцитов. Процесс старения эритроцитов идет двумя путями - кренированием (образование зубцов на плазмолемме) или путем инвагинации участков плазмолеммы. При кренировании образуются эхиноциты с различной степенью формирования выростов плазмолеммы, впоследствии отпадающих, при этом формируется эритроцит в виде микросфероцита. При инвагинации плазмолеммы эритроцита образуются стоматоциты, конечной стадией которых также является микросфероцип. Одним из проявлений процессов старения эритроцитов является их гемолиз, сопровождающийся выхождением гемоглобина; при этом в крови обнаруживаются "тени" (оболочки) эритроцитов. Обязательной составной частью популяции эритроцитов являются их молодые формы A - 5 %, называемые ретикулоцитами, или полихроматофильными эритроцитами. В них сохраняются рибосомы и эндоплазматическая сеть, формирующие зернистые и сетчатые структуры (substantia granulofilamentosa), которые выявляются при специальной суправитальной окраске. При обычной гематологической окраске азур П-эозином они в отличие от основной массы эритроцитов, окрашивающихся в оранжево-розовый цвет (оксифилия), проявляют полихроматофилию и окрашиваются в серо-голубой цвет.